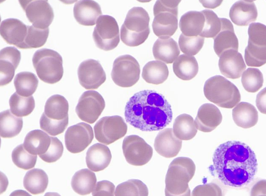

Anatomy- Tissues
0.0(0)
0.0(0)
New
Card Sorting
1/9
There's no tags or description
Looks like no tags are added yet.
Study Analytics
Name | Mastery | Learn | Test | Matching | Spaced |
|---|
No study sessions yet.
10 Terms
1
New cards

Adipose (fat cells); under the skin around the eyes
2
New cards

Areolar; under the skin, binding skin to underlying structures
3
New cards

Dense Connective; ligaments and tendons
4
New cards

Cartilage: ears, nose, ends of bones
5
New cards

bone; skeletal system
6
New cards
blood cell; circulates all over body
7
New cards

Skeletal muscle; attached to the bones
8
New cards

smooth muscle; linear digestive track, uterus, bladder
9
New cards

cardiac muscle; in the walls of the heart
10
New cards

Nervous: brain, spinal cord, nerves